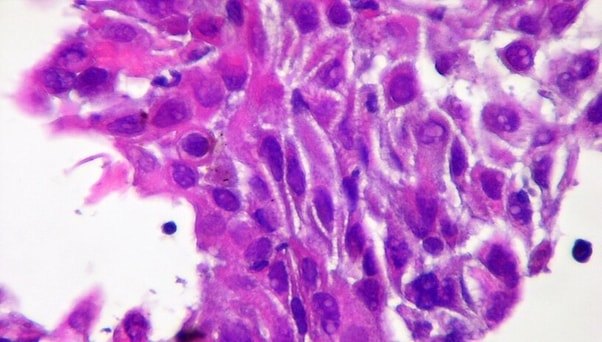
Squamous Cell Carcinoma Patients, at High Risk for Contracting the New

If you are looking for National Cancer Control Month: What Can you do on this Month you've came to the right place. We have 9 Images about National Cancer Control Month: What Can you do on this Month like Squamous Cell Carcinoma Patients, at High Risk for Contracting the New, National Cancer Control Month: What Can you do on this Month and also Public Choice Forum: Worst Side Effects of SMOKING. Read more:
National Cancer Control Month: What Can You Do On This Month
 www.consumerhealthdigest.com
www.consumerhealthdigest.com cancer control chart causes month national disease health awareness
Public Choice Forum: Worst Side Effects Of SMOKING
smoking effects cancer lung side heart looks choice slideshow improves quitting health
Radon Dangers And Risks - Denver Radon Mitigation Systems - Radon
radon cancer risk smokers lung mitigation
Study Links Gum Disease To Cancer In Older Women - Harvard Health
 www.health.harvard.edu
www.health.harvard.edu gum disease cancer health older study links harvard thinkstock
The Content – Science Education Enhances Knowledge (SEEK)
 sites.duke.edu
sites.duke.edu nicotine cancer tobacco diseases piechart every seek enhances knowledge science education illnesses many types
Asbestos Siding: Is It Safe Or Dangerous? — Allthingshome.ca | Steve
 allthingshome.ca
allthingshome.ca asbestos siding shingles baileylineroad allthingshome repainting
Stone Cold - The 11 Most Dangerous Minerals - Mining Technology
crocidolite dangerous minerals asbestos most stone mineral cold
Plutonium Facts, Symbol, Discovery, Properties, Uses
plutonium elements facts pu most dangerous radioactive uses interesting planetdeadly properties toxic deadly chemical lethal rings
Squamous Cell Carcinoma Patients, At High Risk For Contracting The New
www.elglaw.com
www.elglaw.com squamous infection contracting
Gum disease cancer health older study links harvard thinkstock. Plutonium elements facts pu most dangerous radioactive uses interesting planetdeadly properties toxic deadly chemical lethal rings. Squamous infection contracting

0 Comments